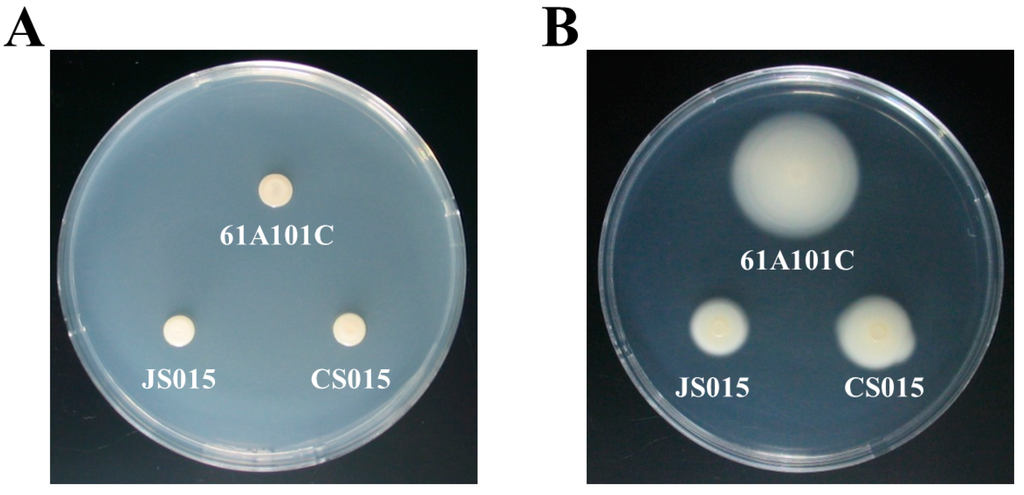

Abstract
We cloned and sequenced the waaL (rfaL) gene from Bradyrhizobium japonicum, which infects soybean and forms nitrogen-fixing nodules on soybean roots. waaL has been extensively studied in the lipopolysaccharide (LPS) biosynthesis of enteric bacteria, but little is known about its function in (brady)rhizobial LPS architecture. To characterize its role as O-antigen ligase in the LPS biosynthesis pathway, we constructed a waaL knock-out mutant and its complemented strain named JS015 and CS015, respectively. LPS analysis showed that an LPS structure of JS015 is deficient in O-antigen as compared to that of the wild type and complemented strain CS015, suggesting that WaaL ligates the O-antigen to lipid A-core oligosaccharide to form a complete LPS. JS015 also revealed increased cell surface hydrophobicity, but it showed decreased motility in soft agar plates. In addition to the alteration in cell surface properties, disruption of the waaL gene caused increased sensitivity of JS015 to hydrogen peroxide, osmotic pressure, and novobiocin. Specifically, plant tests revealed that JS015 failed to nodulate the host plant soybean, indicating that the rhizobial waaL gene is responsible for the establishment of a symbiotic relationship between soybean and B. japonicum.
1. Introduction
The soil bacterium Bradyrhizobium japonicum symbiotically infects its host plant soybean (Glycine max, L. Merr) and forms nitrogen-fixing nodules on soybean roots. The first step in this nodulation process could be signal exchanges between two partners following bacterial attachment to root hairs of soybeans, which requires intimate bacterial cell-to-host cell interactions [,,]. Exchange of signaling molecules such as plant-derived isoflavonoids and bacterium-derived Nod factors induces multiple changes in genetic and physiological properties of both partners [,,,,]. Included are expression of nodulation genes, root hair curling, infection thread formation, and ultimately nodule formation. Specifically, surface components of B. japonicum cells can be an important factor that determines infection capability and nodulation feasibility.
Lipopolysaccharide (LPS) is a major component found in rhizobial cell envelope and has been known to be involved in establishing a symbiotic relationship with leguminous plants. Rhizobial LPS structure and genes involved in its biosynthesis have been elucidated: three distinct regions of a lipid A, a core oligosaccharide, and an O-antigen side chain polysaccharide []. Several mutation studies on LPS biosynthesis pathways revealed that LPS mutants either failed to form normal nitrogen-fixing nodules or formed non-nitrogen-fixing pseudonodules [,,,]. In addition, our mutant studies on the 5.5 kb LPS-gene region previously identified in B. japonicum 61A101C showed that mutation of either rfaD, rfaF, lpcC, or galE encoding heptose epimerase, heptosyl transferase, mannosyl transferase, or glucose epimerase, respectively, affects initiation and maintenance of the nodulation process [,,,,]. Here, we further analyze the downstream region of rfaD and identify another open reading frame (ORF), waaL (formerly rfaL), presumably encoding O-antigen ligase in B. japonicum.
In enteric bacteria, WaaL is involved in LPS-core assembly and ligates the O-antigen to lipid A-core oligosaccharide to form a complete LPS []. Interestingly, WaaL proteins of Escherichia coli K-12 and Salmonella enterica serovar Typhimurium do not share substantial primary-sequence similarity, but they have strikingly similar hydropathy plot patterns []. Both proteins appear to be integral membrane proteins comprising 10 or more potential membrane-spanning domains [,]. WaaL proteins have also been identified in rhizobia [] as well as many other bacterial species, including Vibrio fischeri [], Pseudomonas aeruginosa [], and Erwinia amylovora []. However, little is known about the role of waaL in the symbiotic relationship between leguminous plants and nitrogen-fixing rhizobia, especially soybean endosymbiont B. japonicum. Here, we characterize the waaL gene and thereby extend our list of genes involved in the B. japonicum LPS biosynthesis. We constructed a waaL mutant strain to examine and compare its cell surface properties and symbiotic capability with the wild type. We conclude that waaL is another essential gene responsible for the successful symbiotic nitrogen fixation.
2. Results and Discussion
2.1. Identification of the B. japonicum waaL (rfaL) Gene
In a previous study, we identified a 5.5-kb gene region involved in LPS synthesis of B. japonicum 61A101C and characterized rfaD, rfaF, lpcC, and galE encoding heptose epimerase, heptosyl transferase, mannosyl transferase, and glucose epimerase, respectively, [,,,,]. Further sequence analysis of the downstream region of rfaD revealed an additional ORF whose deduced amino acid sequences (426 amino acids in length) exhibited 100% identity with an rfaL gene, encoding an O-antigen ligase, from Bradyrhizobium elkanii. Interestingly, this BLAST search (http://blast.ncbi.nlm.nih.gov/Blast.cgi) also showed significant similarities with rfaL genes from a number of Bradyrhizobium species including B. liaoningense, B. yuanmingense, B. oligotrophicum, and B. japonicum. Similarities of the top 100 hits range from 64% to 99%. The same species, but different strain B. japonicum USDA110 possesses a gene locus with 82% similarity. Surprisingly, this locus (bll5926) was annotated as an unknown protein in Rhizobase (http://genome.microbedb.jp/RhizoBase).
In addition, the BLAST search result demonstrates that most, if not all, of top 100 hits contain Wzy_C superfamily domain (pfam04932) whose sequence is located between 200th and 354th amino acid positions. This domain is known to be involved in the synthesis of O-antigen and thus representing O-antigen ligases such as enteric WaaL (previously known as RfaL); however, none of the top 100 hits is from enteric bacteria including E. coli and Salmonella. Therefore, we directly compared amino acid sequences of 61A101C rfaL with those of E. coli waaL. Their sequence homology revealed only ca. 14% amino acid identity. This could be a common feature that WaaL proteins are highly variable, even among different serotypes within the same species []. Despite the low sequence similarity, the hydropathy profile of the 61A101C RfaL protein was highly similar to WaaL proteins from E. coli and Salmonella (Figure 1), suggesting that rhizobial RfaL and enteric WaaL proteins have similar enzymatic function. Hydropathy profiles have been used to identify potential genes encoding WaaL proteins [,]. Based on the BLAST search and hydropathy profile analysis, we suggest that the B. japonicum 61A101C rfaL encodes an O-antigen ligase and its function is likely in agreement with other enteric WaaL proteins. Moreover, hereafter we rename rfaL to waaL, at least, in rhizobial strains because the waa locus is a new gene name related to LPS biosynthesis.
2.2. A B. japonicum waaL Mutant Shows Different LPS Profiles
To characterize a function of waaL in the B. japonicum LPS biosynthesis, a waaL mutant (JS015) and its complemented strain (CS015) were constructed as described in the experimental section and their LPS profiles were compared to the wild type (Figure 2). SDS-PAGE analysis showed that the wild-type LPS contained both LPS-I (i.e., high molecular weight) and LPS-II (i.e., low molecular weight) bands, whereas the JS015 LPS displayed only the LPS-II band, which is an indicative of lacking O-antigen. It has been known for B. japonicum and Rhizobium phaseoli that LPS-I and LPS-II bands represent a complete form of LPS and truncated LPS (i.e., LPS without O-antigen), respectively [,].

Figure 1.
Comparison of hydropathy plots of WaaL proteins from E. coli (a); S. enterica serovar Typhimurium (b); and B. japonicum 61A101C (c). The x-axis represents the amino acid residue position, while the y-axis represents the relative hydrophobicity score. Peaks above the red line indicate potential membrane-spanning domains. Each protein contains 12 potential membrane-spanning domains.

Figure 2.
SDS-PAGE of LPS from wild-type, waaL knock-out mutant, and complemented strains. LPS I is the high molecular weight form of the LPS, which contains the O-antigen. LPS II lacks the O-antigen. Lane 1, LPS standard from E. coli serotype 055:B5 (Invitrogen, Carlsbad, CA, USA); Lane 2, 61A101C; Lane 3, JS015; Lane 4, CS015.
Our finding indicated that the abnormal LPS structure lacking O-antigen present in JS015 could be due to the loss of O-antigen ligase activity. The LPS profile of CS015 was found to be identical to that of the wild type (Figure 2). Thus, the results confirmed the ligase role of WaaL to connect the O-antigen to the outer core of LPS in B. japonicum.
2.3. Lack of O-Antigen Increases the Cell Surface Hydrophobicity
Our previous studies on the LPS-deficient mutants revealed that their cell surface was more hydrophobic than that of the wild type [,]. As expected, JS015 also had increased hydrophobicity of its cell surface compared to the wild type and its complemented strain CS015 (Figure 3A). This result suggests that O-antigen composition of LPS is important to maintain a physiological nature of the B. japonicum cell surface, which is crucial in the intimate interaction between the bacterium and its host soybean (see, Section 2.6 nodulation result). Interestingly, when we observed cell pellet patterns after centrifugation, the patterns between JS015 and wild-type cell pellets were quite discernable. JS015 had a relatively long cell pellet pattern compared to the wild type and CS015 (Figure 3B). This result is consistent with cell pellet patterns of the previous LPS-deficient mutants [,].

Figure 3.
Cell surface hydrophobicity (A) and cell pellet pattern (B) of three B. japonicum strains: 1, 61A101C; 2, JS015; 3, CS015. (A) The x-axis represents removal rate per min as a function of the hexadecane-to-water volume ratio (VH/VW), while the y-axis represents hexadecane-to-water volume ratios (VH/VW).
2.4. The waaL Mutant Is Less Motile
In addition to surface hydrophobicity, other surface properties such as attachment and motility can be affected by the lack of O-antigen []. Thus, we compared motility among the wild type, JS015, and CS015 using the soft agar (0.3%) assay. JS015 showed significantly less motility than the wild type and CS015, even though the phenotype of CS015 was not fully restored (Table 1 and Figure 4B). We also carried out the control experiment using 1% solid agar plates, since the different growth rates between the wild type and JS015 may affect the motility. Generation times of the wild type, JS015, and CS015 were 8.5 ± 0.3, 11.8 ± 0.4, and 9.3 ± 0.8 h, respectively. Regardless of the growth rate, there was no difference among the three strains in the control experiment (Figure 4A). These results confirm that the decreased swimming motility in JS015 was due to defect in motility function rather than the slower growth rate. However, we wondered whether it was due to the loss of flagella or physical/structural regulation in motility apparatus (e.g., flagellum is intact, but its motion was limited by incomplete LPS and/or increased hydrophobicity). To determine this, the morphology of the three strains was observed by transmission electron microscopy (TEM) (Figure 5). The wild type shows several polar flagella, while JS015 appears to have no flagellum in its cell surface structure (Figure 5). Interestingly, CS015 restored some flagella, but not all, which explains partial complementation in the swimming motility assay. These results indicate that the decreased swimming motility by the disruption of the waaL gene in B. japonicum was due to a defect in flagella production. Our finding is also consistent with an observation made by Abeyrathne et al. [], in that in P. aeruginosa, the lack of WaaL resulted in reductions in swimming and twitching motility and flagella production. Several other studies have also shown impaired motility in waaL mutants of V. fischeri [], E. amylovora [], and Proteus mirabilis [].

Table 1.
Characteristics of three B. japonicum strains in motility, nodulation, and stress responses.
Strains | Motility (mm in Diameter) | Osmotic Stress a (% Survivability) | Oxidative Stress b (Zone Inhibition Size in mm) | Novobiocin a (% Survivability) | Nodulation c |
---|---|---|---|---|---|
61A101C | 33.0 ± 1.5 A | 106.4 ± 5.1 A | 30.7 ± 0.4 A | 92.5 ± 3.4 A | + |
JS015 | 12.3 ± 0.9 B | 94.2 ± 4.2 B | 39.0 ± 0.7 B | 64.7 ± 9.0 B | − |
CS015 | 20.8 ± 0.6 C | 109.2 ± 7.1 A | 34.7 ± 2.2 A | 88.7 ± 7.1 A | + |
Values followed by different capital letters are statistically significant (p < 0.05) based on Student’s t test. Three biological replicates were used for each experiment except for nodulation assay. a Osmotic (50 mM NaCl) and novobiocin (20 µg·mL−1) stresses were calculated based on the initial cell number (100%); b Oxidative stress was calculated based on zone inhibition size after application of 5 µL of 3% (v/v) H2O2 onto the filter disk; c Nodule numbers were counted after 4 weeks of soybean growth. + indicates successful nodule formation, while − indicates there is no nodule formation. Plants inoculated with 61A101C or CS015 formed ca. 8 nodules per plant, whereas no nodules were formed in plants inoculated with JS015.
Figure 4.
Motility of three B. japonicum strains 61A101C, JS015, and CS015: (A) 1% solid agar medium; and (B) 0.3% soft agar medium.

Figure 5.
Electron microscopic analysis of flagella from the wild type (A); the waaL knock-out mutant (B); and its complemented strain (C). Bars = 5 µm.
2.5. The waaL Mutant Is More Sensitive to Oxidative, Osmotic, and Novobiocin Stresses
Rhizobia may be exposed to various types of stresses before and during the nodulation process, including nutrient limitation, oxidative stress, and changes in osmolarity as well as toxic molecules [,,,,]. For successful nodule development, it is essential that bacteria should survive and/or maintain in critical numbers for a long time in the rhizosphere or within the host plant []. Despite the mutual interaction in the symbiosis, host plants produce an oxidative burst (e.g., hydrogen peroxide) as a defense mechanism []. Thus, rhizobia have to be able to resist the plant’s innate defense mechanism to initiate nodulation. In addition to oxidative stress, salinity is another environmental factor that leads to reduced nodulation process [].
Osmotic stress also affects root hair deformation and induces cell death []. To investigate the effect of the waaL gene on bacterial stress response to oxidative and osmotic stresses, we compared survivability of CS015 with that of JS015 when they were exposed to those stresses. JS015 showed more susceptibility to both oxidative and osmotic stresses as compared to the wild type and CS015 (Table 1). These results indicate that the lack of O-antigen in LPS affects bacterial sensitivity to hydrogen peroxide and survivability to osmotic stress.
In most Gram-negative bacteria, LPS can provide an effective permeability barrier against small hydrophobic molecules (e.g., hydrophobic antibiotics), allowing bacterial growth and survival in an unfavorable environment. We evaluated whether mutation on the waaL gene could affect bacterial susceptibility to novobiocin, a hydrophobic antibiotic that was used to isolate novobiocin-supersensitive (NS) mutants of E. coli []. In E. coli, most of NS mutants were found to have defective LPS, specifically such as a lack of external outer-core oligosaccharides. Similarly, high sensitivity to novobiocin was observed in JS015 compared with the wild type and CS015 (Table 1). These results indicate not only that alteration in LPS composition caused by mutations leads to the increased sensitivity to novobiocin, but also that O-antigen could be the primary structural constituent responsible for the function of LPS as a permeability barrier.
2.6. waaL Is Required for Successful Nodule Formation on Soybean Roots
Since a number of studies showed failure in nodulation of rhizobial LPS mutants deficient in O-antigen [,], we tested whether JS015 also failed to form mature nodules on soybean roots. Unlike the wild type, JS015 was not able to develop nodules (Figure S1). However, CS015 restored the ability to form functional nodules (Table 1). This result indicates that WaaL is one of the key players to induce and maintain a symbiotic relationship in nitrogen fixation between soybean and its symbiont B. japonicum.
3. Experimental Section
3.1. Bacterial Strains, Plasmids, and Growth Conditions
The bacterial strains and plasmids used in this study are described in Table 2. The B. japonicum strains were aerobically cultured in an AG medium [] at 30 °C. The E. coli strains were aerobically cultured in Luria–Bertani (LB) medium at 37 °C. Antibiotics were used at the following concentrations when needed: chloramphenicol, 30 µg·mL−1; kanamycin, 150 µg·mL−1; streptomycin 100 µg·mL−1 for B. japonicum and ampicillin, 50 µg·mL−1; kanamycin, 50 µg·mL−1; and streptomycin, 50 µg·mL−1 for E. coli.

Table 2.
Bacterial strains and plasmids.
Strains/Plasmids | Relevant Characteristics | Reference or Source |
---|---|---|
B. japonicum | ||
61A101C | Wild type, Cmr | Nitragin (Milwaukee, WI, USA) |
JS015 | Strain 61A101C waaL::Km, Kmr | This study |
CS015 | JS015/pBBRL, Smr, Kmr | This study |
E. coli | ||
DH5α | supE44, ΔlacU169 (Φ80 lacZΔM15), hsdR17, recA1, endA1, gyrA96, thi-1, relA1 | Invitrogen (Carlsbad, CA, USA) |
S17-1 | recA pro (RP4-2Tet::Mu Kan::Tn7) | [] |
Plasmids | ||
pGEM-T easy | PCR cloning vector, Ampr | Promega (Madison, WI, USA) |
p34s-Km | Vector containing Kmr cassette, Kmr | [] |
pTRL | pGEM T easy vector containing 1.5 kb fragment of waaL gene, Ampr | - |
pTRLK | pTRL derivative waaL gene disruption by deletion of BssHII fragment and insertion of Kmr cassette, Kmr | - |
pJQ200SK | Suicide vector, sacB, Gmr | [] |
pJQRLK | pJQ200SK-waaL::Km, Gmr, Kmr | This study |
pIJ778 | pBluescript KS(+) derivative containing the streptomycin/spectinomycin resistance gene aadA, Smr | [] |
pBBR1MCS-2 | Broad host range expression vector, mod, rep, lacZ, Kmr | [] |
pBBRL | pBBR1MCS-2 carrying the 1.5 kb fragment of waaL gene, Kmr | This study |
pBBRL-Sm | pBBRL derivative containing the Smr gene, Kmr gene disruption by deletion of NcoI fragment, Smr | This study |
3.2. DNA Sequence Analysis
Restriction enzymes were purchased from TaKaRa Biotechnology (Dalian, China) and were used according to the supplier’s specifications. Plasmid DNA was extracted with a LaboPass™ plasmid DNA purification kit (Cosmo Genetech, Seoul, Korea). When needed, DNA was purified from the agarose gel by using a LaboPass™ Gel Extraction Kit (Cosmo Genetech, Seoul, Korea). The T4 DNA ligase was purchased from TaKaRa Biotechnology (Dalian, China). DNA was quantified using a Nanodrop Technologies ND-1000 spectrophotometer (Nano-Drop Technologies, Wilmington, DE, USA). Sequence homology searches were performed by using the BLAST algorithm at the National Center for Biotechnology Information. Hydropathy profiles of various WaaL proteins were plotted using the Kyte–Doolittle algorithm with a window size of 9 []. The nucleotide sequence of the B. japonicum waaL gene has been submitted to GenBank under the accession number KC172899.
3.3. Construction of a waaL Mutant and Its Complemented Strain
A waaL mutant strain was constructed by deletion of the gene and insertion of a kanamycin-resistance cassette into the coding sequence using the sacB-based suicide vector pJQ200SK []. Briefly, a 1.5-kb fragment containing the waaL gene and its upstream and downstream regions was PCR-amplified and subcloned into the pGEM-T Easy vector (Promega, Madison, WI, USA), resulting in pTRL. Then, the waaL gene was disrupted by deleting the internal 220-bp BssHII fragment spanning 55th and 274th nucleic acid positions and replacing it with the 1.2-kb kanamycin-resistance cassette from p34S-Km [], which results in pTRLK. The disrupted waaL gene fragment was then cloned into the PstI site in pJQ200SK, creating pJQRLK. With bi-parental mating, pJQRLK was transferred from E. coli S17-1 to B. japonicum 61A101C. Lastly, the waaL mutant strain created by double-crossover recombination was selected on AG agar plates containing chloramphenicol (30 µg·mL−1), kanamycin (150 µg·mL−1), and 5% sucrose. The sacB gene of pJQ200SK was used as a positive selection marker for double-crossover recombination events against single-crossover recombination. The resulting waaL mutant was named JS015 and its gene disruption was confirmed by colony PCR.
To construct a waaL-complemented strain, the waaL gene fragment excised from pTRL using KpnI and XbaI was cloned into KpnI-XbaI sites of pBBR1MCS-2 [], creating pBBRL. Then, the 1.3-kb streptomycin-resistance cassette from pIJ778 [] was inserted into the SacI site of pBBRL and part of the kanamycin cassette was removed by deletion of the 401-bp NcoI fragment, resulting in the replacement of kanamycin cassette with streptomycin-resistance gene. The resulting plasmid pBBRL-Sm was introduced into JS015 by bi-parental mating. The complemented strain was named CS015 and verified by colony PCR.
3.4. LPS Profile Analysis
LPSs were extracted as described by Carrion et al. [] and analyzed by sodium dodecyl sulfate-polyacrylamide gel electrophoresis (SDS-PAGE). After SDS-PAGE, LPSs were visualized on a gel strained with Pro-Q® Emerald 300 LPS stain kits purchased from Molecular Probes (Eugene, OR, USA).
3.5. Cell Surface Hydrophobicity Analysis
Hydrophobicity on the cell surface was determined by the microbial adhesion to hydrocarbon (MATH) assay as described previously []. Hexadecane was used as a hydrocarbon source and the percentage of MATH was calculated as follows: % MATH = {(A0 − At)/A0} × 100, where A0 is the initial optical density and At is the optical density of the cell suspension at time t.
3.6. Motility and Transmission Electron Microscope (TEM) Analysis
B. japonicum cells were harvested at mid-log phase by centrifugation at 8000× g and washed with phosphate-buffered saline (PBS, pH 7.0). All strains of B. japonicum were then resuspended in PBS to adjust OD600 = 0.5. Aliquots of 5 µL of the bacterial suspensions were placed on the 0.3% AG agar plate and incubated for 7 days at 30 °C. The motility was quantified by measuring the diameter of cell diffusion. To observe the bacterial flagella, TEM images of the B. japonicum cells were obtained with a LEO 912 AB energy-filtered TEM (Carl Zeiss Inc., Berlin, Germany, Korea Basic Science Institute, Chuncheon, Korea) operated at 120 kV. Cells were placed on the grids and stained for 10 min each with 4% uranyl acetate, washed with distilled water, air-dried, and examined under the TEM.
3.7. H2O2 Inhibition Zone Assay
A filter disk assay was performed as described by Jeon et al. [] with modification. B. japonicum cells exponentially grown in AG broth were collected by centrifugation (6000× g, 10 min, 4 °C), washed twice with PBS, and adjusted to an OD600 of 1.0. Then, 100 µL of the cell suspension was spread on AG agar plates. A sterilized filter disk of 5 mm in diameter was placed in the center of the agar plates, and 5 µL of 3% (v/v) H2O2 was applied onto the filter disk. The inhibition zones were measured in millimeters after the plates were incubated at 30 °C for 7 days.
3.8. Osmotic Stress and Novobiocin Sensitivity Assay
Sensitivity of B. japonicum cells to osmotic stress and novobiocin was evaluated by viable cell count (e.g., CFU·mL−1). Cell suspension with an OD600 of 1.0 prepared as described above was 10-fold serially diluted (10−1 to 10−6). Then, 10 µL of each diluted aliquot was spotted onto AG agar plates containing 50 mM NaCl or 20 µg·mL−1 novobiocin. After 7 days of incubation at 30 °C, CFUs were counted and % survivability was calculated based on the initial cell number as 100%.
3.9. Nodulation Assay
Laboratory-scale nodulation assays were performed using plastic growth pouches (Mega International, Minneapolis, MN, USA). As described by Lee et al. [], soybean seeds (Glycine max L. cv. Williams) were surface-sterilized and germinated in petri dishes for 2–3 days. Each seedling, with a root length between 2 and 3 cm, was aseptically placed in autoclaved pouches and inoculated with 1 mL of the bacterial suspension (OD600 = 0.1) of 61A101C, JS015, or CS015. The seedlings were grown in a growth chamber with 16 h light/8 h dark at 26 °C and watered with half-strength Broughton & Dilworth (B&D) medium [] when needed. A total of 18 plants were harvested after 4 weeks of growth, and nodule numbers were counted.
4. Conclusions
In this study, JS015 exhibited altered phenotypes including incomplete LPS, increased surface hydrophobicity, decreased motility, and increased sensitivity toward hydrogen peroxide, osmotic stress, and novobiocin. Among them, incomplete LPS resulting from inactivation of the waaL gene likely affected the outcome of the other phenotype changes. Ultimately, lack of O-antigen in the B. japonicum LPS has an immediate and vital influence on failure of nodulation in soybeans. Our findings support the notion that (i) O-antigen ligase encoded by waaL is a key enzyme in the B. japaponicum cell wall biosynthesis, which links the O-antigen to the outer core of LPS and (ii) intact rhizobial LPS is important not only to establish successful symbiotic relationships, but also to provide resistance against a host defense mechanism, such as oxidative burst, and other environmental fluctuations.
Supplementary Materials
Supplementary materials can be found at http://www.mdpi.com/1422-0067/16/08/16778/s1.
Acknowledgments
We thank Dylan Parks for his critical reading of the manuscript. This work was supported, in part, by the Basic Science Research Program through the National Research Foundation of Korea (NRF) funded by the Ministry of Education, Science and Technology (2010-0016797) and an Inha University Research grant.
Author Contributions
Jun-Gu Noh, Han-Eul Jeon, Jae-Seong So and Woo-Suk Chang designed the experiment; Jun-Gu Noh and Han-Eul Jeon conducted the experiment; Woo-Suk Chang conducted statistical analysis; and Jun-Gu Noh, Jae-Seong So and Woo-Suk Chang wrote the manuscript.
Conflicts of Interest
The authors declare no conflict of interest.
References
- Stacey, G.; So, J.-S.; Roth, L.E.; Lakshmi, S.B.; Carlson, R.W. A lipopolysaccharide mutant of Bradyrhizobium japonicum that uncouples plant from bacterial differentiation. Mol. Plant Microbe Interact. 1991, 4, 332–340. [Google Scholar] [CrossRef] [PubMed]
- Park, K.M.; So, J.-S. Altered cell surface hydrophobicity of lipopolysaccharide-deficient mutant of Bradyrhizobium japonicum. J. Microbiol. Methods 2000, 41, 219–226. [Google Scholar] [CrossRef]
- Janczarek, M.; Rachwal, K.; Marzec, A.; Grzadziel, J.; Palusinska-Szysz, M. Signal molecules and cell-surface components involved in early stages of the legume-rhizobium interactions. Appl. Soil Ecol. 2015, 85, 94–113. [Google Scholar] [CrossRef]
- Kobayashi, H.; Naciri-Graven, Y.; Broughton, W.J.; Perret, X. Flavonoids induce temporal shifts in gene-expression of nod-box controlled loci in Rhizobium sp. NGR234. Mol. Microbiol. 2004, 51, 335–347. [Google Scholar] [CrossRef] [PubMed]
- Lang, K.; Lindemann, A.; Hauser, F.; Göttfert, M. The genistein stimulon of Bradyrhizobium japonicum. Mol. Genet. Genomics 2008, 279, 203–211. [Google Scholar] [CrossRef] [PubMed]
- Halverson, L.J.; Stacey, G. Signal exchange in plant-microbe interactions. Microbiol. Rev. 1986, 50, 193–225. [Google Scholar] [PubMed]
- Hirsch, A.M.; Fujishige, N.A. Molecular signals and receptors: Communication between nitrogen-fixing bacteria and their plant hosts. In Biocommunication of Plants; Witzany, G., Baluska, F., Eds.; Springer: Berlin, Germany, 2012; pp. 255–280. [Google Scholar]
- Hassan, S.; Mathesius, U. The role of flavonoids in root-rhizosphere signaling: Opportunities and challenges for improving plant-microbe interactions. J. Exp. Bot. 2012, 63, 3429–3444. [Google Scholar] [CrossRef] [PubMed]
- Carrion, M.; Bhat, U.R.; Reuhs, B.; Carlson, R.W. Isolation and characterization of the lipopolysaccharides from Bradyrhizobium japonicum. J. Bacteriol. 1990, 172, 1725–1731. [Google Scholar] [PubMed]
- Carlson, R.W.; Kalembasa, S.; Turowski, D.; Pachori, P.; Noel, K.D. Characterization of the lipopolysaccharide from a Rhizobium phaseoli mutant that is defective in infection thread development. J. Bacteriol. 1987, 169, 4923–4928. [Google Scholar] [PubMed]
- Campbell, G.R.; Reuhs, B.L.; Walker, G.C. Chronic intracellular infection of alfalfa nodules by Sinorhizobium meliloti requires correct lipopolysaccharide core. Proc. Natl. Acad. Sci. USA 2002, 99, 3938–3943. [Google Scholar] [CrossRef] [PubMed]
- Cava, J.R.; Elias, P.M.; Turowski, D.A.; Noel, K.D. Rhizobium leguminosarum CFN42 genetic regions encoding lipopolysaccharide structures essential for complete nodule development on bean plants. J. Bacteriol. 1989, 171, 8–15. [Google Scholar] [PubMed]
- Noel, K.D.; Duelli, D.M. Rhizobium lipopolysaccharide and its role in symbiosis. In Prokaryotic Nitrogen Fixation: A Model System for Analysis of a Biological Process; Triplett, E.W., Ed.; Horizon Scientific Press: Wymondham, UK, 2000; pp. 415–431. [Google Scholar]
- So, J.-S. Molecular cloning of a gene region from Bradyrhizobium japonicum essential for lipopolysaccharide synthesis. FEMS Microbiol. Lett. 1991, 83, 299–303. [Google Scholar] [CrossRef]
- So, J.-S.; Kim, W.-S.; Stacey, G. Molecular characterization of a gene region involved in lipopolysaccharide biosynthesis in Bradyrhizobium japonicum: Cloning, sequencing and expression of rfaF gene. FEMS Microbiol. Lett. 2000, 190, 109–114. [Google Scholar] [CrossRef] [PubMed]
- Noh, J.; Kim, D.-H.; Oh, E.-T.; So, J.-S. Characterization of the rfaD gene region of Bradyrhizobium japonicum 61A101C. J. Microbiol. Biotechnol. 2002, 12, 826–828. [Google Scholar]
- Chang, W.-S.; Park, K.-M.; Koh, S.-C.; So, J.-S. Characterization of the Bradyrhizobium japonicum galE gene: Its impact on lipopolysaccharide profile and nodulation of soybean. FEMS Microbiol. Lett. 2008, 280, 242–249. [Google Scholar] [CrossRef] [PubMed]
- Lee, H.-I.; In, Y.-H.; Jeong, S.-Y.; Jeon, J.-M.; So, J.-S.; Chang, W.-S. Inactivation of the lpcC gene alters surface-related properties and symbiotic capability of Bradyrhizobium japonicum. Lett. Appl. Microbiol. 2014, 59, 9–16. [Google Scholar] [CrossRef] [PubMed]
- Schnaitman, C.A.; Klena, J.D. Genetics of lipopolysaccharide biosynthesis in enteric bacteria. Microbiol. Rev. 1993, 57, 655–682. [Google Scholar] [PubMed]
- Klena, J.D.; Pradel, E.; Schnaitman, C.A. Comparison of lipopolysaccharide biosynthesis genes rfaK, rfaL, rfaY, and rfaZ of Escherichia coli K-12 and Salmonella typhimurium. J. Bacteriol. 1992, 174, 4746–4752. [Google Scholar] [PubMed]
- Ormeno-Orrillo, E.; Menna, P.; Almeida, L.G.P.; Ollero, F.J.; Nicolas, M.F.; Rodrigues, E.P.; Nakatani, A.S.; Batista, J.S.S.; Chueire, L.M.O.; Souza, R.C.; et al. Genomic basis of broad host range and environmental adaptability of Rhizobium tropici CIAT 899 and Rhizobium sp. PRF 81 which are used in inoculants for common bean (Phaseolus vulgaris L.). BMC Genomics. 2012, 13, 735. [Google Scholar] [PubMed]
- Post, D.-M.; Yu, L.; Krasity, B.C.; Choudhury, B.; Mandel, M.J.; Brennan, C.A.; Ruby, E.G.; McFall-Ngai, M.J.; Gibson, B.W.; Apicella, M.A. O-antigen and core carbohydrate of Vibrio fischeri lipopolysaccharide composition and analysis of their role in Euprymna scolopes light organ colonization. J. Biol. Chem. 2012, 287, 8515–8530. [Google Scholar] [CrossRef] [PubMed]
- Abeyrathne, P.D.; Daniels, C.; Poon, K.K.; Matewish, M.J.; Lam, J.S. Functional characterization of WaaL, a ligase associated with linking O-antigen polysaccharide to the core of Pseudomonas aeruginosa lipopolysaccharide. J. Bacteriol. 2005, 187, 3002–3012. [Google Scholar] [CrossRef] [PubMed]
- Berry, M.C.; McGhee, G.C.; Zhao, Y.; Sundin, G.W. Effect of a waaL mutation on lipopolysaccharide composition, oxidative stress survival, and virulence in Erwinia amylovora. FEMS Microbiol. Lett. 2009, 291, 80–87. [Google Scholar] [CrossRef] [PubMed]
- Heinrichs, D.E.; Yethon, J.A.; Whitfield, C. Molecular basis for structural diversity in the core regions of the lipopolysaccharides of Escherichia coli and Salmonella enterica. Mol. Microbiol. 1998, 30, 221–232. [Google Scholar] [CrossRef] [PubMed]
- Morgenstein, R.-M.; Clemmer, K.M.; Rather, P.N. Loss of the WaaL O-antigen ligase prevents surface activation of the flagellar gene cascade in Proteus mirabilis. J. Bacteriol. 2010, 192, 3213–3221. [Google Scholar] [CrossRef] [PubMed]
- Lee, Y.-W.; Jeong, S.-Y.; In, Y.-H.; kim, K.-Y.; So, J.-S.; Chang, W.-S. Lack of O-polysaccharide enchances biofilm formaion by Bradyrhizobium japonicum. Lett. Appl. Microbiol. 2010, 50, 452–456. [Google Scholar]
- Chang, W.-S.; Franck, W.L.; Cytryn, E.; Jeong, S.; Joshi, T.; Emerich, D.W.; Sadowsky, M.J.; Xu, D.; Stacey, G. An oligonucleotide microarray resource for transcriptional profiling of Bradyrhizobium japonicum. Mol. Plant Microbe Interact. 2007, 20, 1298–1309. [Google Scholar] [CrossRef] [PubMed]
- Carrasco, J.A.; Armario, P.; Pajuelo, E.; Burgos, A.; Caviedes, M.A.; Lopez, R.; Chamber, M.A.; Palomares, A.J. Isolation and characterisation of symbiotically effective Rhizobium resistant to arsenic and heavy metals after the toxic spill at the Aznalcollar pyrite mine. Soil Biol. Biochem. 2005, 37, 1131–1140. [Google Scholar] [CrossRef]
- Donati, A.J.; Jeon, J.-M.; Sangurdekar, D.; So, J.-S.; Chang, W.-S. The genome-wide transcriptional and physiological responses of Bradyrhizobium japonicum to paraquat-mediated oxidative stress. Appl. Environ. Microbiol. 2011, 77, 3633–3643. [Google Scholar] [CrossRef] [PubMed]
- Jeon, J.-M.; Lee, H.-I.; Donati, A.J.; So, J.-S.; Emerich, D.W.; Chang, W.-S. Whole-genome expression profiling of Bradyrhizobium japonicum in response to hydrogen peroxide. Mol. Plant Microbe Interact. 2011, 24, 1472–1481. [Google Scholar] [CrossRef] [PubMed]
- Vriezen, J.A.C.; de Bruijn, F.J.; Nusslein, K. Responses of rhizobia to desiccation in relation to osmotic stress, oxygen, and temperature. Appl. Environ. Microbiol. 2007, 73, 3451–3459. [Google Scholar] [CrossRef] [PubMed]
- Morgan, J.A.W.; Bending, G.D.; White, P.J. Biological costs and benefits to plant-microbe interactions in the rhizosphere. J. Exp. Bot. 2005, 56, 1729–1739. [Google Scholar] [CrossRef] [PubMed]
- Munoz, V.; Ibanez, F.; Tordable, M.; Megias, M.; Fabra, A. Role of reactive oxygen species generation and Nod factors during the early symbiotic interaction between bradyrhizobia and peanut, a legume infected by crack entry. J. Appl. Microbiol. 2014, 118, 182–192. [Google Scholar] [CrossRef] [PubMed]
- Singleton, P.W.; Bohlool, B.B. Effect of salinity on nodule formation by soybean. Plant Physiol. 1984, 74, 72–76. [Google Scholar] [CrossRef] [PubMed]
- Muñoz, N.; Robert, G.; Melchiorre, M.; Racca, R.; Lascano, R. Saline and osmotic stress differentially affects apoplastic and intracellular reactive oxygen species production, curling and death of root hair during Glycine max L.–Bradyrhizobium japonicum interaction. Environ. Exp. Bot. 2012, 78, 76–83. [Google Scholar] [CrossRef]
- Tamaki, S.; Sato, T.; Matsuhashi, M. Role of lipopolysaccharides in antibiotic resistance and bacteriophage adsorption of Escherichia coli K-12. J. Bacteriol. 1971, 105, 968–975. [Google Scholar] [PubMed]
- Sadowsky, M.J.; Tully, R.E.; Cregan, P.B.; Keyser, H.H. Genetic diversity in Bradyrhizobium japonicum serogroup 123 and its relation to genotype-specific nodulation of soybean. Appl. Environ. Microbiol. 1987, 53, 2624–2630. [Google Scholar] [PubMed]
- Simon, R.; Priefer, U.; Puhler, A. A braod host range mobilization system for in vivo genetic engineering—Transcposon mutagenesis in Gram-negative bacteria. Nat. Biotechnol. 1983, 1, 784–791. [Google Scholar] [CrossRef]
- Dennis, J.J.; Zylstra, G.J. Plasposons: Modular self-cloning minitransposon derivatives for rapid genetic analysis of gram-negative bacterial genomes. Appl. Environ. Microbiol. 1998, 64, 2710–2715. [Google Scholar] [PubMed]
- Quandt, J.; Hynes, M.F. Versatile suicide vectors which allow direct selection for gene replacement in gram-negative bacteria. Gene 1993, 127, 15–21. [Google Scholar] [CrossRef]
- Gust, B.; Challis, G.L.; Fowler, K.; Kieser, T.; Chater, K.F. PCR-targeted Streptomyces gene replacement identifies a protein domain needed for biosynthesis of the sesquiterpene soil odor geosmin. Proc. Natl. Acad. Sci. USA 2003, 100, 1541–1546. [Google Scholar] [CrossRef] [PubMed]
- Kovach, M.E.; Elzer, P.H.; Hill, D.S.; Robertson, G.T.; Farris, M.A.; Roop, R.M., II; Peterson, K. Four new derivatives of the broad-host-range cloning vector pBBR1MCS, carrying different antibiotic-resistance cassettes. Gene 1995, 166, 175–176. [Google Scholar]
- Kyte, J.; Doolittle, R.F. A simple method for displaying the hydropathic character of a protein. J. Mol. Biol. 1982, 157, 105–132. [Google Scholar] [CrossRef]
- Rosenberg, M.; Gutnick, D.; Rosenberg, E. Adherence of bacteria to hydrocarbons—A simple method for measuring cell-surface hydrophobicity. FEMS Microbiol. Lett. 1980, 9, 29–33. [Google Scholar] [CrossRef]
- Lee, H.-I.; Lee, J.-S.; Park, K.-H.; Sangurdekar, D.; Chang, W.-S. Effect of soybean coumestrol on Bradyrhizobium japonicum nodulation ability, biofilm formation, and transcriptional profile. Appl. Environ. Microbiol. 2012, 78, 2896–2903. [Google Scholar] [CrossRef] [PubMed]
- Broughton, W.; Dilworth, M. Control of leghaemoglobin synthesis in snake beans. Biochem. J. 1971, 125, 1075–1080. [Google Scholar] [PubMed]
© 2015 by the authors; licensee MDPI, Basel, Switzerland. This article is an open access article distributed under the terms and conditions of the Creative Commons Attribution license (http://creativecommons.org/licenses/by/4.0/).